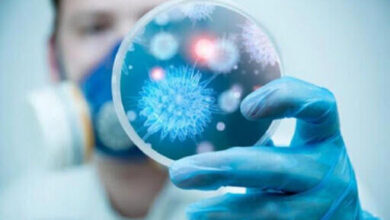

جامعه
-
طلب۱۷ هزار میلیاردی شهرداری تهران از دولت/تعدیل بدهی شهرداری به بانکها و پیمانکاران
معاون مالی و اقتصادی شهرداری تهران از تعدیل بدهی شهرداری به بانکها و پیمانکاران در سال جاری به عنوان یک…
بیشتر بخوانید » -
خطر افزایش ارتفاع آب اقیانوسها و دریاها برای کشورها
۱۸ خردادماه روزی برای آشنایی مردم با تاثیر فعالیتهای انسانی، گرمایش جهانی و تغییر اقلیمی روی اقیانوسها، تالابها و پهنههای…
بیشتر بخوانید » -
بیمارستانهایی که اخطار آتشنشانی دارند، اما نمیتوان آنها را تعطیل کرد
رئیس دانشگاه علوم پزشکی تهران از اقدامات انجام شده در جهت شناسایی ابنیه پرخطر تحت پوشش این دانشگاه خبر داد…
بیشتر بخوانید » -
وزش باد شدید و خیزش گرد و خاک در نقاط مختلف کشور
رئیس مرکز ملی پیشبینی و مدیریت بحران مخاطرات وضع هوا از رگبار باران و خیزش گرد و خاک و کاهش…
بیشتر بخوانید » -
کاهش احتمال طغیان سفیدبالکها در سال جاری
معاون پایش اداره کل محیط زیست و توسعه پایدار شهرداری تهران با تشریح وضعیت سفیدبالکها در تهران میگوید: خبری از…
بیشتر بخوانید » -
علل موفقیت ایران در کنترل همهگیری کرونا
رییس مرکز تحقیقات بیماریهای نوپدید و بازپدید انستیتو پاستور ایران ضمن تشریح شرایط کنترل همهگیری کووید۱۹ در ایران و جهان…
بیشتر بخوانید » -
حداقل سن ثبتنام در پایه اول/شرایط ثبتنام درپیش از دبستانی و دبستان
بر اساس دستورالعمل اجرایی ثبتنام دانشآموزان در سال تحصیلی ۱۴۰۲-۱۴۰۱، مقررات ثبتنام در مقطع پیش از دبستان و دبستان و…
بیشتر بخوانید » -
پیام سید محمد خاتمی در پی درگذشت حجه الاسلام محمود دعایی
️ سید محمد خاتمی: دلِ قهرمانِ دعایی به آهنگ جاذبه می طپید 📝 حجت الاسلام والمسلمین سید محمد خاتمی رییس…
بیشتر بخوانید » -
پیام تسلیت مقام معظم رهبری در پی درگذشت حجه الاسلام محمود دعایی
به نقل از پایگاه اطلاع رسانی دفتر مقام معظم رهبری، حضرت آیتالله خامنهای، رهبر انقلاب اسلامی، در پیامی درگذشت مبارز قدیمی و…
بیشتر بخوانید » -
سید محمود دعایی؛ بزرگمردی که نظیر نداشت
انا لله و انا الیه راجعون با نهایت تاسف و اندوه، روح بلند عالم بزرگوار، استاد اخلاق و سید جلیل…
بیشتر بخوانید »